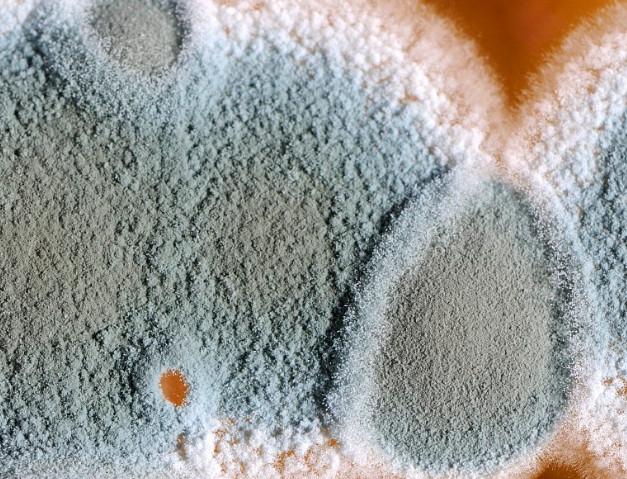
腐烂的水果中,含有较高的就是展青霉素,长期的摄入会引起消化系统的

展青霉素

有实验表明,展青霉素具有影响生育,致癌和免疫等毒理作用,同时也是一
图片尺寸1000x615
青霉素
图片尺寸800x800
第十二周,急诊科急救药品知识系列学习-注射用青霉素钠.
图片尺寸1200x1351
青霉素
图片尺寸640x442![同位素内标u-[13c7]-展青霉素(patulin)- 25 08g/ml](https://i.ecywang.com/upload/1/img2.baidu.com/it/u=3594252194,890751561&fm=253&fmt=auto&app=138&f=JPEG?w=750&h=500)
同位素内标u-[13c7]-展青霉素(patulin)- 25 08g/ml
图片尺寸3000x2000
健康:为何现在青霉素的使用率越来越低了?真相原来是这样!
图片尺寸551x385
青霉素无毒副作用,现在为什么不使用?
图片尺寸695x530
青霉素是治愈梅毒的特效药
图片尺寸600x450
在我国,为什么国产青霉素可以在短时间内快速发展成规模?
图片尺寸650x432
青霉素皮试知多少
图片尺寸1078x1095
五,红霉素青霉素将红霉素和青霉素放在碗中后,用适量的开塞露浸泡5
图片尺寸1137x1136
注射用青霉素钠 0.48g*80万
图片尺寸800x800
张女士托朋友从济宁紧急寄到济南的注射用苄星青霉素. 读者供图
图片尺寸530x397
健康假日这样的水果伤肝伤肾还可能致癌家里有的赶紧扔
图片尺寸1080x1250
锦鲤擦伤烂身注射用青霉素钠比黄粉还见效
图片尺寸2080x1560
青霉素v钾片
图片尺寸3448x3448
展青霉素
图片尺寸500x500
展青霉素是由展青霉产生的一种聚酮类次生代谢产物,青霉属,曲霉属,丝
图片尺寸720x516
青霉素】有医用价值
图片尺寸844x980
腐烂的水果中,含有较高的就是展青霉素,长期的摄入会引起消化系统的
图片尺寸627x479




![同位素内标u-[13c7]-展青霉素(patulin)- 25 08g/ml](https://i.ecywang.com/upload/1/img2.baidu.com/it/u=3594252194,890751561&fm=253&fmt=auto&app=138&f=JPEG?w=750&h=500)


















![同位素内标u-[13c7]-展青霉素(patulin)- 25 08g/ml](https://img.jdzj.com/UserDocument/2017z/pribolab/Picture/201711161410141095.jpg)